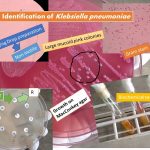

Tag: identification of Klebsiella
Klebsiella pneumoniae : Introduction, Pathogenicity, Laboratory Diagnosis and Treatment
 Introduction of Klebsiella pneumoniae Klebsiella pneumoniae scientific classification is as...
Introduction of Klebsiella pneumoniae Klebsiella pneumoniae scientific classification is as...
Introduction of Klebsiella pneumoniae Klebsiella pneumoniae scientific classification is as...
Introduction of Klebsiella pneumoniae Klebsiella pneumoniae scientific classification is as...